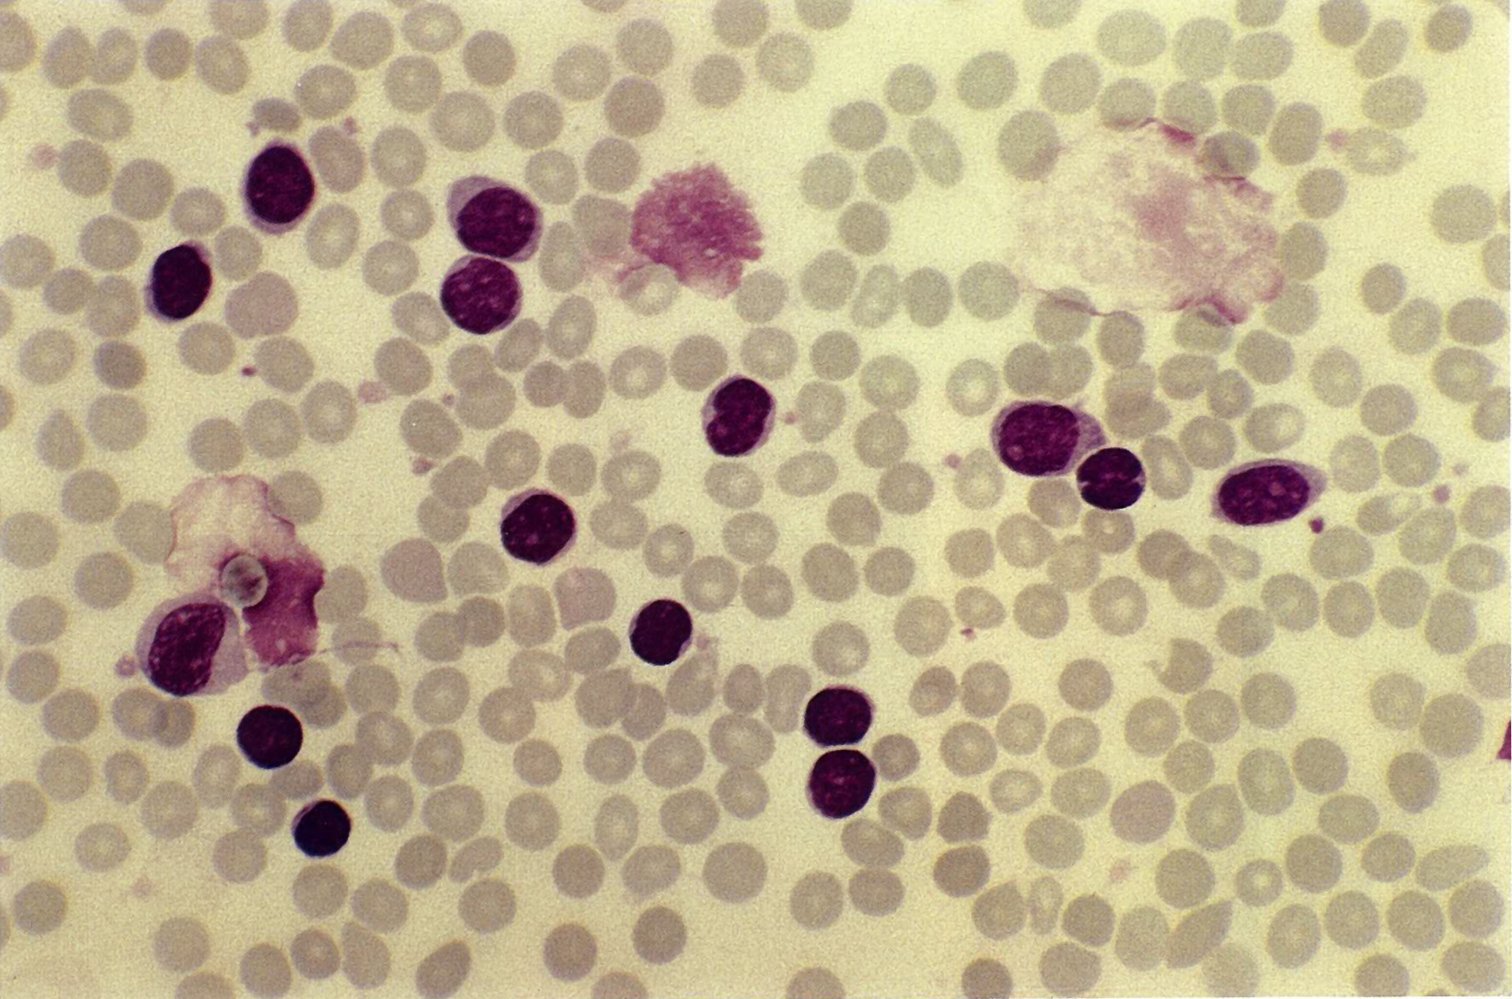
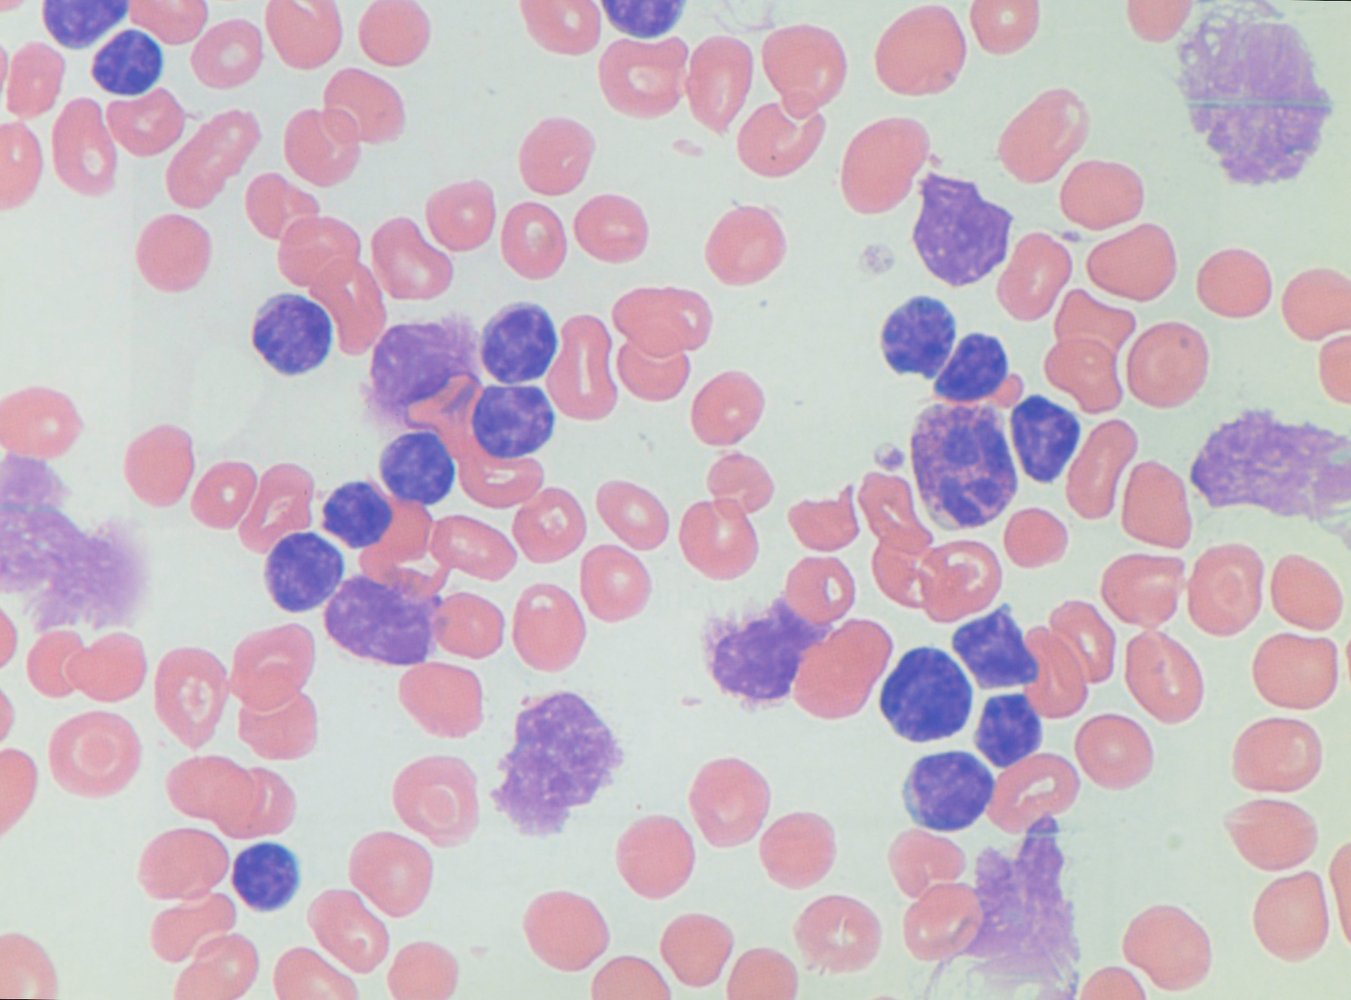
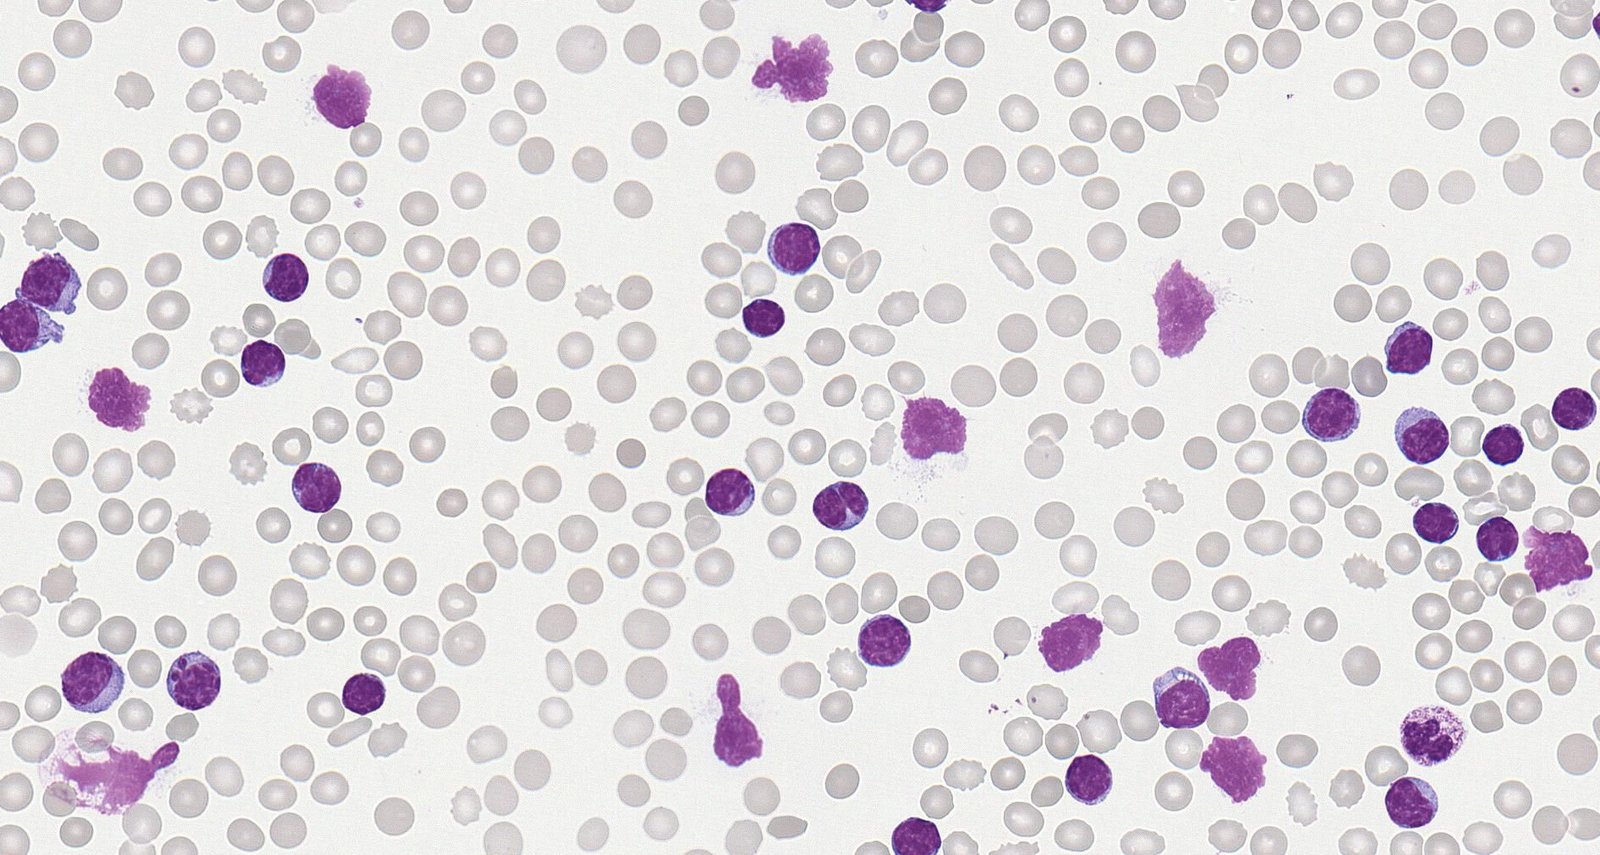

Chronic lymphocytic leukemia (CLL) is a type of B-cell malignancy that manifests with lymphocytic leukocytosis. CLL is the most common type of leukemia in adults and is typically diagnosed in older individuals (≥ 65 years of age). Clinical features include painless lymphadenopathy, fatigue, chronic pruritus, and increased susceptibility to infections. However, most cases are asymptomatic and diagnosed based on incidental laboratory findings. Diagnosis requires persistent monoclonal B-cell lymphocytosis (≥ 5000 cells/mm3 for ≥ 3 months) with immunophenotypic markers consistent with CLL on flow cytometry. Peripheral blood smear typically shows a high percentage of small mature lymphocytes and smudge cells (Gumprecht shadows). Several molecular markers are used to predict prognosis and guide treatment, the most important being the negative prognostic markers del(17p) and TP53 mutation. Advances in targeted therapy have improved patient outcomes in CLL and small molecule inhibitors (e.g., ibrutinib, venetoclax) are now first-line treatment for most patients. Chemoimmunotherapy may be an effective alternative for some patients. Patients with low-risk disease (Rai stage 0) should be managed expectantly. Allogeneic stem cell transplantation is a curative treatment option but is often not possible because of the older age and multiple comorbidities of most patients with CLL.
- Chronic lymphocytic leukemia: a type of proliferative B-cell malignancy that manifests with lymphocytic leukocytosis [1]
- Small lymphocytic lymphoma (SLL): a type of B-cell lymphoma with the same genetic and molecular markers as CLL that manifests primarily in the lymph nodes, bone marrow, and other lymphatic tissue rather than with leukocytosis [1][2]
Some sources classify CLL as a low-grade non-Hodgkin lymphoma because the origin cell is likely a mature B lymphocyte. However, as the malignant cells are present in the blood, it is considered to be a leukemia. SLL is the manifestation of this condition in lymphatic tissue, and is therefore considered to be a lymphoma. [1]

- Sex: ♂ > ♀ (∼ 2:1)
- Age: The median age at the time of diagnosis is 70–72 years (incidence of CLL increases with age).
- Most common type of leukemia in adults
References:[3]
Epidemiological data refers to the US, unless otherwise specified.
Risk factors
- Older age
- Environmental factors: organic solvents
- Family history
Acquired mutations in hematopoietic stem cells → increased proliferation of leukemic B cells with impaired maturation and differentiation in the bone marrow, resulting in:
- Suppression of the proliferation of normal blood cells
-
Immunosuppression
- Hypogammaglobulinemia
- Granulocytopenia
- Thrombocytopenia
- Anemia
-
Immunosuppression
- Infiltration of the lymph nodes, liver, and spleen


About half of cases of CLL remain asymptomatic for a long period, resulting in late or incidental diagnosis.
- Weight loss, fever, night sweats, fatigue (B symptoms)
- Painless lymphadenopathy
- Hepatomegaly and/or splenomegaly may occur.
-
Repeated infections
- Severe bacterial infections (e.g., necrotic erysipelas)
- Mycosis (candidiasis)
- Viral infections (herpes zoster)
- Symptoms of anemia and thrombocytopenia
-
Dermatologic symptoms
- Leukemia cutis
- Chronic pruritus
- Chronic urticaria
Lymphadenopathy is a typical finding in lymphoid malignancies such as CLL and helps to differentiate CLL from CML, a myeloid malignancy.
References:[3][4]
General principles [1][2][5]
- Diagnosis requires persistent monoclonal lymphocytosis plus CLL immunophenotype confirmed by flow cytometry.
- Most patients are asymptomatic and evaluated based on incidental laboratory findings.
- Biopsy may be indicated in certain patients, e.g., if the diagnosis is uncertain.
- Refer to hematology or oncology for further evaluation and management.
In patients with confirmed CLL, staging (e.g., using the Rai staging system) and the presence of prognostic markers are used to guide management.
Laboratory studies [1][2][5][6]
Obtain a CBC, peripheral blood smear, and flow cytometry for all patients.
-
Diagnostic criteria
- Persistent (≥ 3 months)lymphocytosis (≥ 5000 cells/mm3) [1][6]
-
CLL immunophenotype confirmed by flow cytometry, including:
- Expression of CD5, CD19, CD20, CD23 [2]
- Light chain restriction (kappa or lambda)
-
Additional findings: may further support the diagnosis
-
Cytopenias
- Anemia (usually normochromic, normocytic): may be caused by AIHA [5][7]
- Thrombocytopenia
- Granulocytopenia
-
Peripheral blood smear may show:
- High percentage of small mature lymphocytes
- Smudge cells (Gumprecht shadows): mature lymphocytes that rupture easily; appear as artifacts on a blood smear [8]
-
Cytopenias
The occurrence of both AIHA and ITP is known as Evans syndrome. [5][6]
In CLL, the smudge cells on a peripheral blood smear look like Crushed Little Lymphocytes.

Prognostic markers in CLL [5]
-
Indications for testing
- Confirmed CLL diagnosis
- Repeat testing prior to initiating or changing treatment
-
Methods [2][5][6]
- Cytogenetic testing
- FISH to assess for common structural chromosomal aberrations in CLL, e.g., del(17p)
- Immunoglobulin heavy chain variable region (IGHV) mutational status
- TP53 mutational status
- Serum studies: β2-microglobulin and LDH
- Cytogenetic testing
-
Interpretation
- Adverse prognosis: e.g., del(17p) , del(11q), TP53 mutation, elevated β2-microglobulin, elevated LDH
- Intermediate prognosis: trisomy 12 [1]
- Favorable prognosis: IGHV mutation , isolated del(13q)
Biopsies [1]
-
Bone marrow aspiration and biopsy [2]
- Not routinely required for diagnosis
- Consider in patients with cytopenias to determine the cause.
- Typical findings in aspirate include a high percentage of small mature lymphocytes.
- Lymph node biopsy: Consider if the diagnosis is uncertain or for the diagnosis of SLL or Richter transformation.

Rai staging system
| Rai staging system [2][6][9] | |||
|---|---|---|---|
| Rai stage | Modified Rai stage | Findings | |
| 0 | Low risk | Isolated lymphocytosis | |
| I | Intermediate risk | Lymphocytosis | PLUS lymphadenopathy |
| II | PLUS hepatomegaly and/or splenomegaly | ||
| III | High risk | PLUS anemia (Hb < 11 g/dL) | |
| IV | PLUS thrombocytopenia (platelets< 100,000/mm3) | ||
Other staging systems [2]
- Binet staging system: commonly used for staging and informing treatment decisions in European countries
- CLL international prognostic index (CLL-IPI): risk stratification score based on age, clinical stage (Rai or Binet), and the presence of prognostic molecular markers
| Binet staging system [2] | ||
|---|---|---|
| Definition | Additional findings | |
| Stage A |
|
|
| Stage B |
|
|
| Stage C |
|
|
- Acute lymphoblastic leukemia (ALL)
- Autoimmune hemolytic anemia (AIHA)
- Mantle cell lymphoma
- Hairy cell lymphoma
The differential diagnoses listed here are not exhaustive.
General principles [2][10]
Management should be specialist guided. Consider enrollment in a clinical trial.
-
Indications for anticancer therapy: based on disease risk (Rai staging) and disease activity[2]
-
Low-risk disease (Rai stage 0)
- Expectant management
- Regular follow-ups to assess for disease progression and indications for treatment [10]
- Intermediate risk disease (Rai stage I or II)
- Consider expectant management if stable and asymptomatic.
- Medical therapy: indicated for progressive or symptomatic disease (i.e., active disease)
- High-risk disease (Rai stage III or IV): medical therapy
-
Low-risk disease (Rai stage 0)
-
Anticancer therapy may include:
- Targeted therapy, e.g., ibrutinib, rituximab, alemtuzumab
- Chemoimmunotherapy, e.g., FCR: fludarabine, cyclophosphamide, rituximab
- Allogeneic HSCT: currently the only curative treatment option (not routinely performed)
CLL is a malignancy with a slow rate of cell division and disease progression. Treatment of low-risk disease is usually not recommended and is unlikely to extend survival.
Pretreatment evaluation [2]
- Clinical assessment: physical examination, and functional status assessment (e.g., ECOG score)
-
Laboratory studies
- CMP: to document baseline organ function [2][5]
- Repeat cytogenetic testing; see “Prognostic markers in CLL.”
- Immunoglobulin levels: to evaluate for hypogammaglobulinemia [5][6]
- Infectious disease serology: for HBV, HCV, HIV, and CMV [2][11]
- Direct Coombs test: to assess for AIHA
-
Imaging
- Chest x-ray: to evaluate for mediastinal lymphadenopathy
- Further imaging is not routinely required for diagnosis unless clinically indicated.
- Further testing (e.g., CT scan, bone marrow biopsy): may be necessary for patients enrolling in clinical trials.

Pharmacotherapy
- The pretreatment evaluation is used to determine which regimen is used.
- In most patients with CLL, a BTK inhibitor or BCL-2 inhibitor is the first-line treatment. [11][12][13]
| Overview of pharmacotherapy for CLL [11][14] | |||
|---|---|---|---|
| Therapy | Examples | Indications | |
| Targeted therapies | Small molecule inhibitors |
|
|
| Monoclonal antibodies |
|
|
|
| Chemoimmunotherapy |
|
|
|
Allogeneic stem cell transplantation [15][16]
- Curative treatment for CLL
- High-risk procedure with a 20% mortality rate [1][15][16]
- Consider for young patients with few or no comorbidities and:
- Del(17p) and/or TP53 mutation
- Disease that is refractory to targeted therapy
Supportive care [2][16]
Evaluate for and manage any complications, including:
-
Infectious diseases
- Ensure routine vaccinations (e.g., influenza, pneumococcus) are up-to-date.
- Consider infection prophylaxis (e.g., HHV, VZV, and PCP prophylaxis ). [16]
- Consider IVIG therapy for patients with hypogammaglobulinemia who have recurrent infections.
- Autoimmune cytopenias: Manage AIHA and ITP (e.g., with glucocorticoids) as needed.
- Complications of anticancer therapy: Consider the need for G-CSF for anticancer therapy-induced myelosuppression.
Live vaccines are contraindicated in patients with CLL because of the risk of severe complications. [2]
Infectious diseases are common in patients with CLL. Evaluating for and managing infectious diseases can reduce the risk of severe illness and complications. [16]
- Immunosuppression with subsequent infections (most common cause of death)
- Secondary malignancies
- Hyperviscosity syndrome
- Autoimmune hemolytic anemia (of both the warm and cold agglutinin type)
-
Richter transformation or Richter syndrome: transformation into a high-grade NHL (usually diffuse large B cell lymphoma)
- Occurrence: ∼ 5% of cases
- Diagnostic indicators:
- Rapidly progressive lymphadenopathy → lymph nodebiopsy required
- New onset of B symptoms
- ↑ LDH
- Treatment: similar to symptomatic CLL and advanced stages
References:[17][18]
We list the most important complications. The selection is not exhaustive.
Prognostic factors [6]
- Older age is associated with a poor overall survival rate.
- Rai staging
- Adverse prognostic markers in CLL, e.g.:
- Del(17p13)
- Elevated β2-microglobulin level
- Blood lymphocyte doubling time: Rapid doubling is associated with a high risk of disease progression.